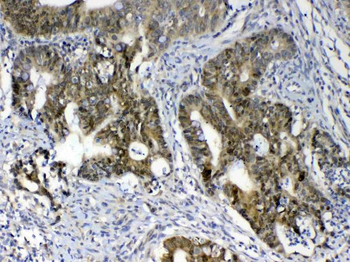
GALE Rabbit Polyclonal Antibody
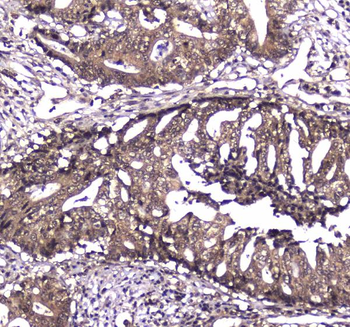
Caspase 4/CASP4 Rabbit Polyclonal Antibody

You have no items in your shopping cart.
All Products
- SAE2/UBA2 Rabbit Polyclonal Antibody [orb402291]
ELISA, FC, ICC, IF, IHC, IHC-Fr, WB
Human, Mouse, Rat
Rabbit
Polyclonal
Unconjugated
100 μg - Myeloperoxidase/MPO Rabbit Polyclonal Antibody [orb402306]
FC, IF, IHC, WB
Human, Mouse, Rat
Rabbit
Polyclonal
Unconjugated
100 μg - Periostin/Postn Rabbit Polyclonal Antibody [orb402458]
ELISA, IHC, WB
Mouse, Rat
Rabbit
Polyclonal
Unconjugated
100 μg - RAB27A Rabbit Polyclonal Antibody [orb402252]
ELISA, FC, ICC, IHC, WB
Human, Mouse, Rat
Rabbit
Polyclonal
Unconjugated
100 μg - DCK Rabbit Polyclonal Antibody [orb402255]
ELISA, FC, IHC, WB
Human, Mouse, Rat
Rabbit
Polyclonal
Unconjugated
100 μg - COPE Rabbit Polyclonal Antibody [orb402549]
FC, ICC, IF, IHC, IHC-Fr, IP, WB
Human, Mouse, Rat
Rabbit
Polyclonal
Unconjugated
100 μg - GALE Rabbit Polyclonal Antibody [orb402376]
ELISA, IHC, WB
Human, Mouse, Rat
Rabbit
Polyclonal
Unconjugated
100 μg - Caspase 4/CASP4 Rabbit Polyclonal Antibody [orb402282]
ELISA, FC, ICC, IF, IHC, WB
Human
Rabbit
Polyclonal
Unconjugated
100 μg - PARK7/DJ1 Rabbit Polyclonal Antibody [orb402400]
ELISA, IHC, WB
Mouse, Rat
Rabbit
Polyclonal
Unconjugated
100 μg - MMP16 Rabbit Polyclonal Antibody [orb402559]
ELISA, FC, ICC, IF, IHC, WB
Human, Mouse, Rat
Rabbit
Polyclonal
Unconjugated
100 μg